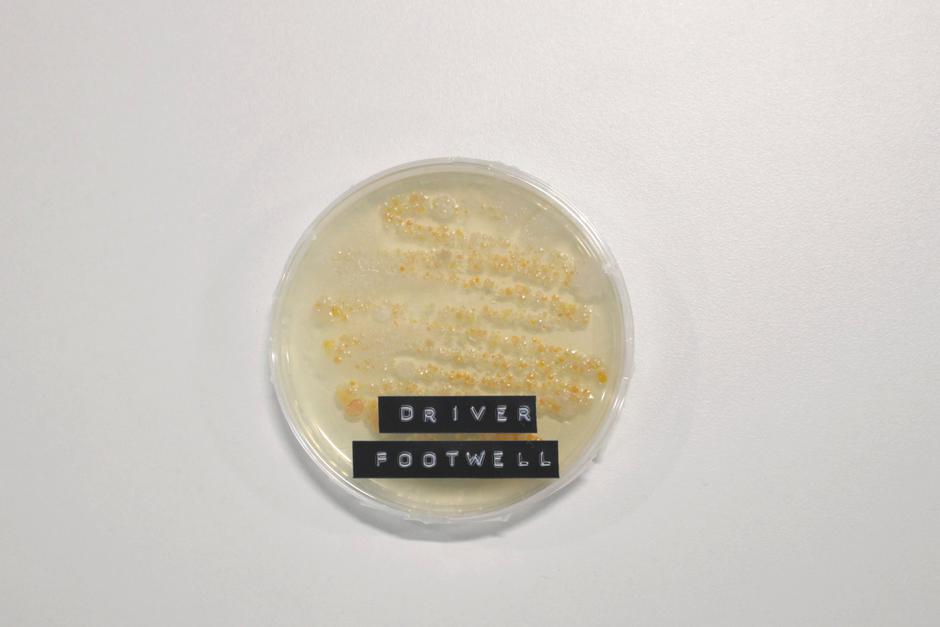
Notranjost avta | Avtor: Motorpoint

Ali čistite stanovanje samo enkrat na pet tednov? Zelo verjetno precej pogosteje. Anketa med nekaj prek tisoč vozniki pa kaže, da notranjost svojega avta v povprečju čistijo le kakih 10-krat na leto, pa čeprav jih velika večina priznava, da v avtu med vožnjo pogosto tudi kaj pojejo in popijejo. Vsak peti pravi, da avto znotraj očisti le trikrat letno, kar deset odstotkov vprašanih pa avta znotraj ne čisti nikoli pogosteje kot dvakrat na leto.
Ne preseneča torej, da je notranjost avta, v katerem mnogi preživijo velik del dneva, lahko pravo gojišče organizmov, tudi takšnih, ki so zdravju škodljivi. Pri britanskem specialisti za rabljena vozila Motorpoint so napravili zanimiv preizkus na avtu, ki ni bil znotraj očiščen že nekaj časa. Avto je bil namenjen tipični vsakodnevni družinski vožnji, v njem so se vozili otroci in tudi pes.
Z dvajsetih točk po vsem avtu so vzeli bris, ga hermetično zaprtega pet dni pustili v laboratoriju, da so se lahko bakterije razbohotile, nato pa opravili strokovno analizo in primerjavo med vzorci.
V nasprotju s splošnim prepričanjem, da sta volanski obroč in prestavna ročica med najbolj umazanimi deli avta, se je izkazalo prav nasprotno - izmed 20 vzorcev z različnih delov avta se je na vzorcu z volana in ročice zadrževalo najmanj bakterij. Tudi vzvratno ogledalo ni problematično.
Nasprotno pa je bil prtljažnik tisti, ki je prava zakladnica zdravju škodljivih organizmov, saj je bil vzorec iz zadnjega dela testiranega avta porazen. Nekaj je imelo pri tem gotovo dejstvo, da je bil testni avto namenjen prevozu psa, a veliko prisotnost organizmov so vzorci dokazali še na tleh pred voznikovim sedežem (odpadki hrane?), na ročici ročne zavore in tudi na gumbu za sprostitev varnostnega pasu.
Razlika med moškim in žensko
Omenjena analiza in vzporedna anketa dokazujeta, da se vozniki premalo zavedajo pomena čiste notranjosti. Anketa je hkrati pokazala tudi razliko med moškimi in ženskami, saj prve bolj zanima čista zunanjost, medtem ko se ženske pogosteje lotijo notranjega čiščenja. Na vsak način bi morali eni in drugi to početi pogosteje.
dezurni@zurnal24.si









In ti voziš avto ne da bi se dotikal volana in ostalih ročic in gumbov. Ti si boljši kot Uri Geller.
Spet pretiravanje s temi bakterijami. Ko berem takale članke me resno zanima, kako je mogoče, da sem sploh še živ: kot otroci smo se igrali zunaj v strupenem pesku, strupeni mivki, živeli smo v bajtah, pobarvanih s strupeno barvo, jedli… ...prikaži veči smo strupene jedi, zdaj se menda vozimo v strupenem avtu... ? Bakterije NISO NUJNO nevarne, če ne živiš v balončku in si tako odporen nanje. V 40 letih vožnje z avtom se še nisem okužil ali zbolel v njem.